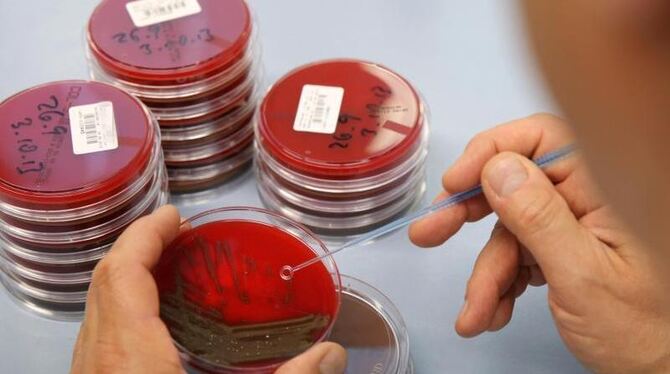

Grünen-Studie: Problem-Keime in Wurstprodukten
Agarplatten mit Bakterienkulturen: Kritiker warnen, dass ESBL-Keime beim Einsatz von Antibiotika ins Fleisch gelangen können. Foto: Bernd Wüstneck/Archiv- und Symbolbild
Lorem ipsum dolor sit amet, consetetur sadipscing elitr, sed diam nonumy eirmod tempor invidunt ut labore et dolore magna aliquyam erat, sed diam voluptua. At vero eos et accusam et justo duo dolores et ea rebum.
